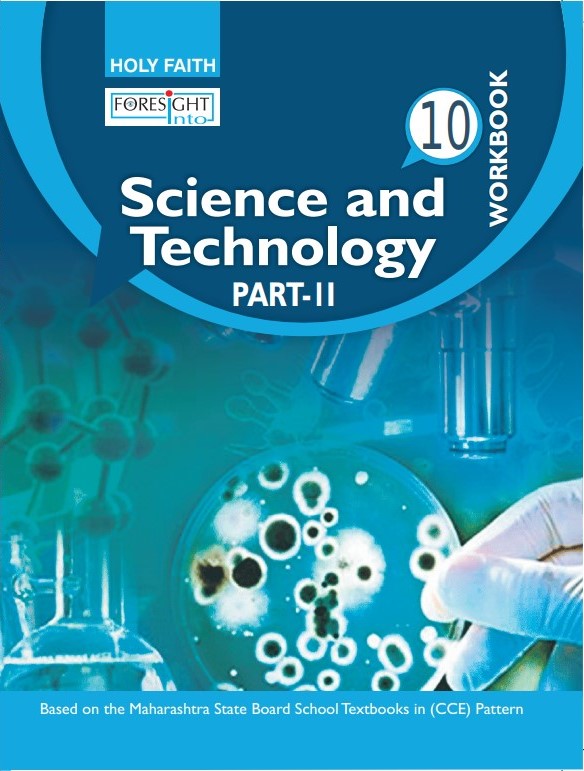

Salient features:-
• Extensive preparation for the CCE (Continuous and Comprehensive Evaluation) Pattern
• Additional Summative and Formative Assessment questions for each chapter
• Scientific process skills based questions - observing, experimenting, classifying, measuring, inferring, concluding and communicating
• 'In a Nutshell' provide complete overview of the chapter
• Includes textual questions
• Ample writing space provided with all questions